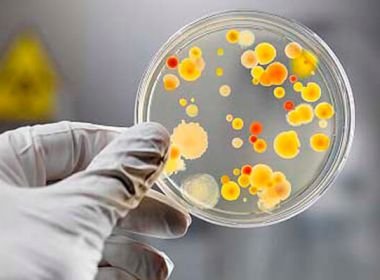
Sociedade Brasileira de Infectologia cita preocupação com fala de Bolsonaro

SaúdeCiúme não é cuidado: psicóloga explica como diferenciar afeto de violência emocionalSaúdeDia da Corrida: fortalecimento muscular é peça-chave para prevenir lesões e melhorar o desempenhoBrasilAnvisa manda recolher lote de água Crystal após detectar bactériaPolíticaLula acusa Flávio Bolsonaro de pedir intervenção dos EUA no PixBahiaTCM determina suspensão de contratos do São João de Irecê e questiona gastos de R$ 10,2 milhões
Saúde

Saúde 07/07/2020 - 13h24
Policlínica Regional de Saúde retoma atendimento em Feira de Santana A unidade de saúde estava fechada desde o final do mês de maio devido à pandemia do coronavírus.

saúde 03/07/2020 - 09h41
Vacinas poderão controlar a doença, mas não o vírus, diz médico do Butantan Segundo Ricardo Palacios, diretor de pesquisa do instituto, será possível apenas evitar que a forma grave do novo coronavírus se desenvolva

saúde 25/06/2020 - 10h04
Novo tipo do vírus da Zika circula no Brasil; Fiocruz-BA prevê possibilidade de epidemia A descoberta foi feita a partir de uma ferramenta que monitora as sequências genéticas do vírus.

Saúde 22/06/2020 - 09h14
Sedentários podem ter sintomas mais intensos do coronavírus, diz pesquisa Levantamento é feito por grupo de pesquisadores brasileiros de diferentes universidades

Bahia 29/05/2020 - 15h31
Sesab entregará medicamentos para doentes crônicos em casa A medida entrou em vigor nesta sexta-feira (29), por meio da portaria 215, da Secretaria da Saúde do Estado (Sesab).

Bahia 29/05/2020 - 09h02
Rui sanciona aplicação de multa a quem divulgar fake news sobre pandemia, epidemia ou endemia Texto prevê pagamento de multa de até R$ 20 mil para aqueles que transmitirem informações falsas sobre os temas

Saúde 22/05/2020 - 15h50
Possível vacina contra Covid-19 apresenta resultados positivos e seguros Ainda assim, novos estudos serão necessários para confirmar se essa resposta imune é capaz de proteger contra uma infecção da Covid-19.

Bahia 22/05/2020 - 08h59
Ministério da Saúde define situação de atenção na Bahia por índices de dengue O documento chama a atenção para a Bahia e o Ceará no Nordeste, São Paulo no Sudeste, Mato Grosso do Sul, Mato Grosso e Distrito Federal no Centro-Oeste e o Paraná no Sul.

Bahia 19/05/2020 - 09h14
Fábrica de remédios na Bahia fecha após ter quatro funcionários infectados com coronavírus Em nota, prefeitura de Santo Antônio de Jesus informou que atividades na empresa ficarão suspensas por 14 dias

Saúde 18/05/2020 - 09h30
Mandetta diz que ampliação do uso da cloroquina pode provocar alta de mortes em casa Questionado sobre a pressão para utilização do medicamento, Mandetta afirmou que a classe política só está interessada na volta ao trabalho

Saúde 30/04/2020 - 10h55
Estudo mostra que novo coronavírus consegue infectar neurônios humanos Próximo passo é saber como essas células são afetadas

Saúde 02/04/2020 - 14h45
Coronavírus já mata mais que a Tuberculose Nesta quinta-feira o número de mortos no mundo já ultrapassa a marca de 5 mil

Covid-19 30/03/2020 - 09h48
Força aérea alemã monta hospital em avião para atender vítimas da Covid-19 Os aviões do tipo MedEvac Airbus, que são projetados para transporte médico serão utilizados.
Saúde 25/03/2020 - 10h24
Sociedade Brasileira de Infectologia cita preocupação com fala de Bolsonaro Em nota, a entidade indicou que a fala de Bolsonaro pode dar falsa impressão que as medidas de isolamento são inapropriadas e que a Covid-19 é semelhante ao resfriado comum.

Saúde 24/03/2020 - 08h57
China testa vacina para Covid-19 com 108 voluntários Voluntários estão divididos em três grupos e receberam as primeiras injeções na última sexta-feira
© Copyright 2026 - Baiano News - Todos os direitos reservados









